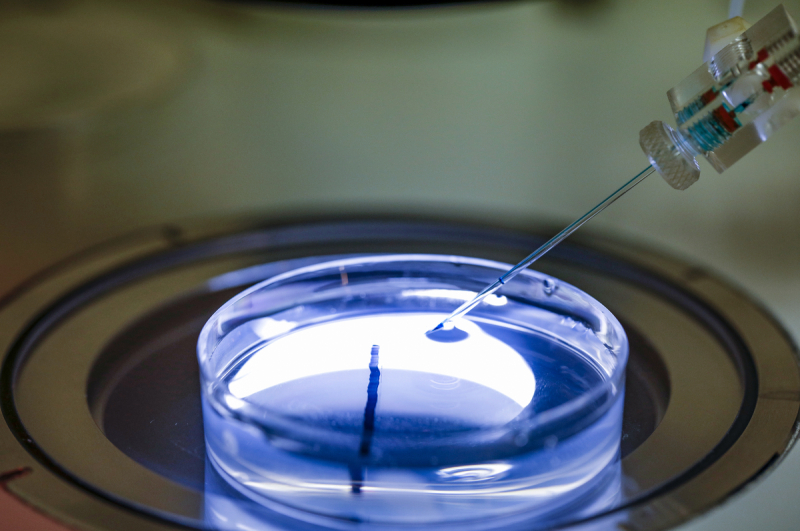
Micro injection d'œufs fécondés d’amphioxus à l’aide d’un micromanipulateur et d’un micro injecteur, impliquant la technique de CRISPR/Cas9

Pourquoi des acteurs de la recherche soutiennent une nouvelle législation européenne sur les OGM
En décembre 2023, le G6, dont fait partie le CNRS, s’est prononcé sur l’utilisation des nouvelles techniques génomiques, quelques mois avant que le Parlement européen ne se prononce ces prochains jours sur l’adaptation de la législation des organismes génétiquement modifiés.
La législation européenne sur les organismes génétiquement modifiés (OGM) pourrait connaître un grand changement. La Commission européenne a ainsi proposé, cet été, une révision de la réglementation pour mieux prendre en compte les évolutions techniques du domaine. Ce texte doit encore être soumis au vote du Parlement européen ; il a reçu le soutien du G6, qui suggère des pistes supplémentaires dans un communiqué publié en ligne.
Le G6, réseau des principaux organismes de recherche européens
Le G6 réunit de manière informelle les principaux organismes de recherche en Europe : le Consiglio Nazionale delle Ricerche en Italie, le CNRS en France, le Consejo Superior de Investigaciones Científicas en Espagne, la Helmholtz Association, la Leibniz Association et la Max Planck Society en Allemagne. Au total, il représente plus de 142 000 collaborateurs et collaboratrices. Il propose des initiatives conjointes et des échanges fréquents sur les sujets abordés par l’Europe de la recherche. Leur argumentaire est ici fondé sur l’émergence, depuis 2018, d’une révolution récente en biologie qui pourrait permettre de réduire considérablement l'utilisation de pesticides et d'engrais dans l'agriculture, tout en renforçant la sécurité alimentaire.
Des ciseaux moléculaires pour modifier le génome
« Il y a un manque d’informations sur les OGM, terme très vaste englobant par exemple les nouvelles techniques génomiques (NGT), insiste Cécile Bousquet-Antonelli, directrice scientifique adjointe (DAS) de CNRS Biologie et directrice de recherche à l’Institut de biologie moléculaire des plantes du CNRS à Strasbourg1 . Les NGT consistent à éditer le génome d’organismes vivants à l’aide de ciseaux moléculaires CRISPR2 , une méthode bien plus rapide et précise que les anciennes approches. Les modifications sont tellement ciblées et efficaces qu’il n’y a plus besoin de passer par la transgénèse, c’est-à-dire l’ajout de gènes d’autres espèces ».
La transgénèse, autorisée dans certains pays, comme les États-Unis, reste en effet interdite en Union européenne, un statut que ni la Commission européenne ni le G6 ne souhaitent changer.
Les NGT s’appuient sur des gènes naturellement observés chez des variétés et des ancêtres d’une même espèce « L’idée est d’autoriser les modifications génétiques qui auraient pu être obtenues par des méthodes classiques, comme les greffes ou le croisement, poursuit la DAS de CNRS Biologie. Si l’on trouve dans la nature un gène intéressant, les NGT permettent d’en bénéficier presque immédiatement ». Elle prend en exemple le téosinte, qui est l’ancêtre commun du maïs. Il existe encore à l’état sauvage au Mexique et ses gènes lui offrent une meilleure résistance à la sécheresse que les cultivars. Les NGT aideraient à conférer ces propriétés à toutes les variétés de maïs et à reproduire ou inhiber des gènes naturellement observés chez des variétés et des ancêtres d’une même espèce. Ce processus assisté est comparable aux centaines, voire aux milliers, de modifications génétiques se déroulant de manière naturelle ou par croisements.
L’absence de gènes étrangers fait qu’il n’est pas possible, à moins de savoir à l’avance quelle séquence a été modifiée, de différencier une plante qui possède un gène par croisement et sélection d’un spécimen qui l’aurait acquis par NGT. En toute rigueur, les scientifiques spécialistes du domaine au sein du G6 considèrent que ces organismes ne devraient pas être classés comme des OGM, au sens populaire du terme.
Cette similitude avec des évolutions naturelles des génomes ou par croisement classiques de plantes pourrait permettre que les végétaux obtenus par NGT puissent être utilisés, sans distinction, dans l’agriculture biologique. Un prolongement qui attire déjà des critiques. « L’agriculture biologique autorise bien, par exemple, l’emploi de la bouillie bordelaise, qui contient du cuivre, ainsi que des fertilisants à base d’azote, tous deux mal assimilés par les plantes, tempère Cécile Bousquet-Antonelli. Tout ce surplus termine dans les nappes phréatiques ».
Poursuivre la recherche sur les NGT en-dehors des serres
Le G6 souligne que les NGT pourraient servir à étudier différents processus biologiques, explorer et améliorer les mécanismes de résistance des plantes aux stress et aux attaques pathogènes, à assurer la sécurité alimentaire face au changement climatique, ainsi qu’à réduire le nombre d’intrants nécessaires aux cultures. Mais pour cela, le G6 propose que les chercheurs et chercheuses puissent cultiver des plantes modifiées par NGT en-dehors de serres strictement contrôlées, ce qui permettrait d’explorer leur développement dans des situations plus variées et plus proches des conditions in natura. Les scientifiques travaillent en effet en modifiant des gènes, puis ils vérifient ce que cela change pour les végétaux sous tout un panel de conditions.
« Ce n’est que comme cela que nous pourrons comprendre comment les plantes s’adaptent à la sécheresse ou à des sols trop calcaires, comment elles trouvent des nutriments, etc., explique Cécile Bousquet-Antonelli. Nous sommes capables de reproduire ces conditions en laboratoire, mais cela reste difficile et incomplet. Et si l’on souhaite combiner plusieurs facteurs, la tâche devient rapidement impossible sans accès à des champs ». C’est en ce sens que le G6 veut augmenter le nombre d’essais d’OGM hors serre.
« La législation actuelle ralentit le développement des travaux de recherche appliquée et des collaborations avec les industriels, poursuit la biologiste. Elle restreint nos capacités à commercialiser des variétés de plantes obtenues par sélection – les cultivars – aux meilleurs rendements et plus résistantes aux pathogènes, tandis que les pays comme les États-Unis, le Chili et l’Australie sont libres de le faire. C’est un véritable enjeu pour l’accroissement des connaissances dans le domaine, et aussi pour la compétitivité et l’emploi ».
La DAS de CNRS Biologie note cependant qu’il ne s’agit en aucun cas, comme c’est souvent le cas dans ces pays qui pratiquent la transgénèse, de créer des variétés immunisées à certains herbicides et pesticides. Cette approche a en effet été dénoncée de nombreuses fois pour les dégâts qu’elle cause à l’environnement. La limitation des intrants, et en particulier des nitrates, doit rester un objectif. Cécile Bousquet-Antonelli cite par exemple, les travaux de certains de nos laboratoires qui concernent aussi bien l’amélioration des outils CRISPR que l’exploration des échanges entre plantes et microorganismes. « On sait que certaines plantes entretiennent des interactions bénéfiques avec des microorganismes au niveau de leurs racines, qui leur permettent de capter et d’utiliser de manière hyper efficace les nutriments naturellement présents dans le sol, précise la scientifique. Or certaines espèces d’intérêt agronomique, entre autres les céréales, ne sont pas capables de telles symbioses. Nos chercheurs travaillent à comprendre comment fonctionnent ces symbioses, et grâce aux NGT, peuvent envisager de conférer aux espèces cultivées la capacité d’interactions avec des microorganismes bénéfiques et ainsi les rendre plus performantes dans leur capacité à tirer leurs nutriments du sol, réduisant alors les intrants nécessaires à leur culture.».
Le CNRS et le G6 ont exposé à des représentants de la Commission et du Parlement européens leurs arguments en faveur de ce changement de législation, ainsi que pour aller encore plus loin. Réponse en février 2024, lors de l'examen de la nouvelle législation au Parlement européen.